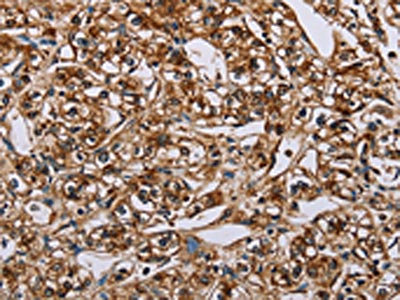

BMP6 Antibody
-
中文名稱:BMP6兔多克隆抗體
-
貨號:CSB-PA787876
-
規格:¥1100
-
圖片:
-
The image on the left is immunohistochemistry of paraffin-embedded Human breast cancer tissue using CSB-PA787876(BMP6 Antibody) at dilution 1/50, on the right is treated with synthetic peptide. (Original magnification: ×200)
-
The image on the left is immunohistochemistry of paraffin-embedded Human prostate cancer tissue using CSB-PA787876(BMP6 Antibody) at dilution 1/50, on the right is treated with synthetic peptide. (Original magnification: ×200)
-
Gel: 8%SDS-PAGE, Lysate: 40 μg, Lane: Mouse heart tissue, Primary antibody: CSB-PA787876(BMP6 Antibody) at dilution 1/500, Secondary antibody: Goat anti rabbit IgG at 1/8000 dilution, Exposure time: 10 seconds
-
-
其他:
產品詳情
-
Uniprot No.:
-
基因名:
-
別名:BMP-6 antibody; Bmp6 antibody; BMP6_HUMAN antibody; Bone morphogenetic protein 6 antibody; Bone Morphogenic Protein 6 antibody; Decapentaplegic vegetal related antibody; DVR6 antibody; HGNC:12686 antibody; TGFB related vegetal related growth factor antibody; Transforming growth factor beta antibody; Vegetal related (TGFB related) cytokine antibody; Vegetal related growth factor (TGFB related) antibody; Vg related sequence antibody; VG-1-R antibody; VG-1-related protein antibody; Vg1 related sequence antibody; VGR antibody; VGR-1 antibody; VGR1 antibody
-
宿主:Rabbit
-
反應種屬:Human,Mouse,Rat
-
免疫原:Synthetic peptide of Human BMP6
-
免疫原種屬:Homo sapiens (Human)
-
標記方式:Non-conjugated
-
抗體亞型:IgG
-
純化方式:Antigen affinity purification
-
濃度:It differs from different batches. Please contact us to confirm it.
-
保存緩沖液:-20°C, pH7.4 PBS, 0.05% NaN3, 40% Glycerol
-
產品提供形式:Liquid
-
應用范圍:ELISA,WB,IHC
-
推薦稀釋比:
Application Recommended Dilution ELISA 1:2000-1:5000 WB 1:500-1:2000 IHC 1:50-1:200 -
Protocols:
-
儲存條件:Upon receipt, store at -20°C or -80°C. Avoid repeated freeze.
-
貨期:Basically, we can dispatch the products out in 1-3 working days after receiving your orders. Delivery time maybe differs from different purchasing way or location, please kindly consult your local distributors for specific delivery time.
-
用途:For Research Use Only. Not for use in diagnostic or therapeutic procedures.
相關產品
靶點詳情
-
功能:Growth factor of the TGF-beta superfamily that plays essential roles in many developmental processes including cartilage and bone formation. Plays also an important role in the regulation of iron metabolism by acting as a ligand for hemojuvelin/HJV. Initiates the canonical BMP signaling cascade by associating with type I receptor ACVR1 and type II receptor ACVR2B. In turn, ACVR1 propagates signal by phosphorylating SMAD1/5/8 that travel to the nucleus and act as activators and repressors of transcription of target. Can also signal through non-canonical pathway such as TAZ-Hippo signaling cascade to modulate VEGF signaling by regulating VEGFR2 expression.
-
基因功能參考文獻:
- The present study demonstrated that BMP6 may protect retinal pigment epithelial cells from oxidative stress injury to a certain extent, which may be associated with alterations in the MAPK signaling pathway. PMID: 29767257
- Study demonstrated that the mesenchymal epithelial/myoepithelial potential of transdifferentiation of the luminal cells that make up the proliferative units is certified by the immunohistochemical expression of some BMP6 purely mesenchymal protein cells. PMID: 28523310
- Plasma BMP6 was significantly increased in chronic heart failure patients. PMID: 27592865
- Our results independently add further evidence to the role of BMP6 mutations as likely contributing factors to late-onset moderate IO unrelated to mutations in the established five HH genes. PMID: 28335084
- Further investigation on clinical ESCC samples and non-tumorous adjacent tissue found that tumors with triple-positive BMP6, ALK2 and BMPRII had deeper growth than tumors with only BMP6 expression PMID: 27959431
- the combined delivery of VEGF and BMP-6 to the bone defect significantly enhanced bone repair through the enhancement of angiogenesis and the differentiation of endogenously recruited MSCs into the bone repair site. PMID: 26475719
- the patients carried genotype TA of rs 267196 and genotype AG of rs267201 present a high risk factor for developing osteonecrosis RR=1.317 and RR=1.3 respectively PMID: 24263212
- BMP-6 upregulates somatostatin receptor actions, leading to reduction of GnRH-induced secretion of luteinizing hormone. PMID: 26779985
- These observations suggest a novel role of BMP-6 in the inhibition of breast cancer metastasis by regulating secretion of MMPs(MMP-1) in the tumor microenvironment. PMID: 26751737
- BMP-dependent physical interaction of VE-cadherin with the BMP receptor ALK2 (BMPRI) and BMPRII, resulting in stabilization of the BMP receptor complex and, thereby, the support of BMP6-Smad signaling. PMID: 26598555
- BMP6 and oxidized low-density lipoprotein independently and synergistically induced osteogenic differentiation and mineralization in vascular endothelial cells. PMID: 26410368
- Identify 3 heterozygous missense mutations in BMP6 in patients with unexplained iron overload. These mutations lead to loss of signaling to SMAD proteins and reduced hepcidin production. PMID: 26582087
- These results demonstrated that Hcy up-regulated hepcidin expression through the BMP6/SMAD pathway, suggesting a novel mechanism underlying the hyperhomocysteinemia-associated perturbation of iron homeostasis. PMID: 26855134
- demonstrate that BMP6 is associated with radiographic severity in AS, supporting the role wingless-type like/BMP pathway on radiographic progression in AS PMID: 25121767
- These observations imply that crosstalk between the VEGF and BMP-6 signaling pathways enhances osteogenic differentiation of MSCs. PMID: 25753222
- In vitro analysis revealed that recombinant BMP6 inhibited the activation of hepatic stellate cells (HSCs) and reduced proinflammatory and profibrogenic gene expression in already activated HSCs PMID: 25011936
- CpG island methylation of BMP6 is found in high frequency in CRC and this epigenetic event is associated with suppressed protein expression in the tumor tissue. PMID: 25227796
- BMP-6 attracted neutrophils and controlled the regulation of the neutrophils in the ovary. PMID: 24406789
- Data indicated that hypermethylation modifications contributed to the regulation of BMP6 and induced an epithelial-to-mesenchymal transition phenotype of breast cancer during the acquisition of drug resistance. PMID: 24890613
- BMP-6 secreted by prostate cancer cells induces IL-6 expression in macrophages; IL-6, in turn, stimulates the neuroendocrine differentiation of prostate cancer cells. PMID: 21374653
- these data highlight a therapeutically innovative role for BMP6 by providing a means to enhance the amount of myogenic lineage derived brown fat. PMID: 24658703
- There were no correlations between iron parameters and the expression of the BMP-6 in granulosa cells from polycycstic ovary syndrome patients. PMID: 24875397
- The BMP-6 staining intensity was downregulated. PMID: 24498236
- WNT5A derived from bone stromal cells induced the expression of BMP-6 by CaP cells; BMP-6 in turn stimulated cellular proliferation of CaP cells. PMID: 24518599
- Marker gene screening for human mesenchymal stem cells in early osteogenic response to bone morphogenetic protein 6 with DNA microarray. PMID: 23799295
- Prostate cancer-derived BMP-6 stimulates tumor-associated macrophages to produce IL-1a through a crosstalk between Smad1 and NF-kB1; IL-1a, in turn, promotes angiogenesis and prostate cancer growth. PMID: 24185914
- High BMP6 expression is associated with breast cancer. PMID: 24012720
- BMP6 plays a critical role in breast cancer cell aberrant proliferation and chemoresistance and may serve as a novel diagnostic biomarker or therapeutic target for breast cancer. PMID: 23674072
- Estrogen is involved in hepcidin expression via a GPR30-BMP6-dependent mechanism PMID: 22792339
- investigated role of BMP6 in esophageal squamous cell carcinoma (SCC) development and progression;high BMP6 activity, defined by strong BMP6 expression with weak noggin or SOST expression, was associated with shorter survival in esophageal SCC patients; results suggest BMP6, noggin and SOST could be used in combination as a prognostic indicator in cancer progression PMID: 22364398
- Results suggest that PTHrP (ParaThyroid Hormone-related Protein) acts upstream of BMP-6, and exerts its antimitogenic effect by reducing BMP-6 mRNA expression through PKA signaling pathway in breast cancer cells. PMID: 20401668
- The methylation of BMP6 was correlated with decreased levels of mRNA transcripts. PMID: 22086350
- Growth differentiation factor 3 is induced by bone morphogenetic protein 6 (BMP-6) and BMP-7 and increases luteinizing hormone receptor messenger RNA expression in human granulosa cells. PMID: 22305102
- BMP-6 mainly inhibited plasmablast differentiation, and BMP-7 mainly induced apoptosis in human memory B cells PMID: 21898381
- BMP6 and iron not only induce hepcidin expression but also induce TMPRSS6, a negative regulator of hepcidin expression PMID: 21622652
- a novel role of BMP-6/HO-1 cascade to relieve breast cancer metastasis by regulating the secretion of growth factors in tumor microenvironment. PMID: 21136273
- AGTR1 gene deletion is associated with congenital anomalies of the kidneys and urinary tract. PMID: 20605837
- the cBMP6 mRNA and H3K27me3 levels revealed significant differences between patients with local local advanced, or metastatic disease PMID: 20573596
- Ass-associated increases in BMP6 expression in a transgenic mouse model of Alzheimer's disease may have deleterious effects on neurogenesis in the hippocampus. PMID: 20844121
- BMP6, Smad1, Smad2 mRNA and protein expression were significantly higher in during sickle-cell pathology with orthopedic complications. PMID: 20460105
- Using BMP-6/7 chimeras, we identified lysine 60 as a key residue conferring noggin resistance within the BMP-6 protein. PMID: 20048150
- Malignant human clear cell renal carcinoma tissue had significantly higher BMP-6 mRNA expression than healthy tissue PMID: 20016212
- regulates hepcidin an iron metabolism in humans PMID: 19765379
- the presence of BMP-6 in adult human articular cartilage indicates a functional role for this growth factor in the maintenance of joint integrity. PMID: 13130469
- BMP-6 increases the levels of osteopontin, BMP-2, alkaline phosphatase and core binding factor alpha 1 mRNAs in human periodontal (HPL) ligament cells. PMID: 15516325
- Recombinant noggin inhibited the function of BMP-6, suggesting a negative feedback regulation of BMP activity and indicating a strategy for the development of a novel therapeutic target in treatment of osteosclerotic bone metastases of prostate cancer PMID: 15548695
- several single nucleotide polymorphisms in bone morphogenic protein 6, annexin A2, and klotho were associated with sickle cell osteonecrosis PMID: 15784727
- In mature human B cells, BMP-6 inhibited cell growth, and rapidly induced phosphorylation of Smad1/5/8 followed by an upregulation of Id1. PMID: 15877825
- endogenous BMP-6 system plays critical roles in aldosterone production between Ang II and K through ERK signaling pathway. PMID: 16527843
- Excess numbers of BMP6-deficient myofibroblast progenitor cells may favour adverse tissue remodelling in patients with diabetes. PMID: 16547600
顯示更多
收起更多
-
亞細胞定位:Secreted.
-
蛋白家族:TGF-beta family
-
數據庫鏈接:
Most popular with customers
-
-
YWHAB Recombinant Monoclonal Antibody
Applications: ELISA, WB, IHC, IF, FC
Species Reactivity: Human, Mouse, Rat
-
Phospho-YAP1 (S127) Recombinant Monoclonal Antibody
Applications: ELISA, WB, IHC
Species Reactivity: Human
-
-
-
-
-